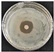

An Efficient Approach for Separating Essential Oil and Polysaccharides Simultaneously from Fresh Leaves of Guajava by Microwave-Mediated Hydrodistillation with Lithium Salts and Antibacterial Activity of Essential Oil
Abstract
1. Introduction
2. Materials and Methods
2.1. Materials and Reagents
2.2. Apparatus
2.3. Experimental Process
2.4. Principal Component Analysis Process
2.5. Essential Oil Detection Conditions
2.6. Bacterial Culture
3. Results and Discussion
3.1. Each Parameter on the Extraction Yield
3.1.1. Influence of Lithium Salt Addition on Yield
3.1.2. Each Parameter on the Yield of EO and Polysaccharide
3.1.3. Kinetic Analysis
3.2. Correlation Analysis
3.3. Principal Component Analysis
3.4. The Response Surface Optimization (RSO) Optimization Process
3.4.1. Influence of Lithium Salt Addition on Yield
3.4.2. Effects of RSO Parameters on the Yield of Polysaccharides
3.4.3. Influence of Response Surface Optimization Factors on Yield
3.4.4. Validation Test
3.5. Comparison with Reference Techniques
3.6. Analysis of EOs Compounds
3.7. Bacteriostatic Activity of EO
4. Conclusions
Author Contributions
Funding
Institutional Review Board Statement
Informed Consent Statement
Data Availability Statement
Conflicts of Interest
References
- De Oliveira, I.; Uchoa, M.A.; Fernandes, M.G.; Vieira, C.R.Y.I.; Faccenda, O.; De Oliveira, I.S.T. Antixenosis of the Triozid, Triozoida limbata (Hemiptera: Triozidae) to Some Cultivars of Psidium guajava (Myrtaceae) in the Field. Fla. Èntomol. 2019, 102, 695–700. [Google Scholar] [CrossRef]
- Manikandan, R.; Anand, A.V. Evaluation of Antioxidant Activity of Psidium guajava Linn. in streptozotocin–Induced Diabetic Rats. Free Radic. Antioxid. 2016, 6, 72–76. [Google Scholar] [CrossRef]
- Husaini, O.; Zulkifli, Z.; Lande, M.L.; Nurcahyani, E. Karakterisasi Bahan Anti Browning dari Ekstrak Air Buah Jambu Batu (Psidium guajava Linn) pada Buah Apel Malang (Malus sylvestris (L.) Mill). J. Penelit. Pertan. Ter. 2017, 17, 85–92. [Google Scholar] [CrossRef][Green Version]
- Ganem, F.; Mattedi, S.; Rodríguez, O.; Rodil, E.; Soto, A. Deterpenation of citrus essential oil with 1-ethyl-3-methylimidazolium acetate: A comparison of unit operations. Sep. Purif. Technol. 2020, 250, 117208. [Google Scholar] [CrossRef]
- Liu, Z.; Qiao, L.; Gu, H.; Yang, F.; Yang, L. Development of Brönsted acidic ionic liquid based microwave assisted method for simultaneous extraction of pectin and naringin from pomelo peels. Sep. Purif. Technol. 2017, 172, 326–337. [Google Scholar] [CrossRef]
- Luo, Y.; Peng, B.; Liu, Y.; Wu, Y.; Wu, Z. Ultrasound extraction of polysaccharides from guava leaves and their antioxidant and antiglycation activity. Process Biochem. 2018, 73, 228–234. [Google Scholar] [CrossRef]
- Yang, Y.-C.; Wang, C.-S.; Wei, M.-C. Development and validation of an ultrasound-assisted supercritical carbon-dioxide procedure for the production of essential oils from Perilla frutescens. LWT 2020, 128, 109503. [Google Scholar] [CrossRef]
- Ju, T.; Xi, J. Continuous extraction optimization, molecular structures and antioxidant activities of polysaccharide from Gracilariopsis lemaneiformis using liquid-phase pulsed discharge. Sep. Purif. Technol. 2019, 236, 116241. [Google Scholar] [CrossRef]
- Singha, K.; Hor, P.K.; Soren, J.P.; Mondal, J.; Mondal, K.C.; Pati, B.R.; Das Mohapatra, P.K. Exploration of bioactive prospects of a polysaccharide fraction from Termitomyces heimii against colorectal cancer and broad spectrum bacteria. Bioact. Carbohydr. Diet. Fibre 2021, 25, 100255. [Google Scholar] [CrossRef]
- Khursheed, R.; Singh, S.K.; Wadhwa, S.; Gulati, M.; Awasthi, A. Therapeutic potential of mushrooms in diabetes mellitus: Role of polysaccharides. Int. J. Biol. Macromol. 2020, 164, 1194–1205. [Google Scholar] [CrossRef]
- Díaz-De-Cerio, E.; Verardo, V.; Gómez-Caravaca, A.M.; Fernández-Gutiérrez, A.; Segura-Carretero, A. Health Effects of Psidium guajava L. Leaves: An Overview of the Last Decade. Int. J. Mol. Sci. 2017, 18, 897. [Google Scholar] [CrossRef]
- Rodríguez-Palafox, E.E.; Vásquez-López, A.; Márquez-Licona, G.; Lima, N.B.; Lagunes-Fortiz, E.; Tovar-Pedraza, J.M. First Report of Colletotrichum siamense Causing Anthracnose of Guava (Psidium guajava) in Mexico. Plant Dis. 2021, 105, 3290. [Google Scholar] [CrossRef]
- Takahashi, Y.; Otsuki, A.; Mori, Y.; Kawakami, Y.; Ito, H. Inhibition of leukocyte-type 12-lipoxygenase by guava tea leaves prevents development of atherosclerosis. Food Chem. 2015, 186, 2–5. [Google Scholar] [CrossRef]
- Sopon, A.; Thongdet, E.; Punnarak, P.; Suksai, S. The Potential of Sea Grapes (Caulerpa Lentilifera) Extracted Polysaccharide as Prebiotics on Inhibiting Pathogenic Bacteria Vibrio Parahaemolyticus. Int. J. Environ. Sci. Dev. 2020, 11, 572–576. [Google Scholar] [CrossRef]
- Chen, B.; Long, Q.-S.; Meng, J.; Zhou, X.; Wu, Z.-B.; Tuo, X.-X.; Ding, Y.; Zhang, L.; Wang, P.-Y.; Li, Z.; et al. Target Discovery in Ralstonia solanacearum through an Activity-Based Protein Profiling Technique Based on Bioactive Oxadiazole Sulfones. J. Agric. Food Chem. 2020, 68, 2340–2346. [Google Scholar] [CrossRef]
- De Araújo, A.C.J.; Freitas, P.R.; dos Santos Barbosa, C.R.; Muniz, D.F.; de Almeida, R.S.; de Menezes, I.R.A.; Ribeiro-Filho, J.; Tintino, S.R.; Coutinho, H.D.M. In Vitro and In Silico Inhibition of Staphylococcus aureus Efflux Pump NorA by α-Pinene and Limonene. Curr. Microbiol. 2021, 78, 3388–3393. [Google Scholar] [CrossRef]
- Freitas, P.R.; de Araújo, A.C.J.; dos Santos Barbosa, C.R.; Muniz, D.F.; de Almeida, R.S.; de Menezes, I.R.A.; da Costa, J.G.M.; Rodrigues, F.F.G.; Rocha, J.E.; Pereira-Junior, F.N.; et al. Inhibition of the MepA efflux pump by limonene demonstrated by in vitro and in silico methods. Folia Microbiol. 2022, 67, 15–20. [Google Scholar] [CrossRef]
- Costa, M.D.S.; Rocha, J.E.; Campina, F.F.; Silva, A.R.; Da Cruz, R.P.; Pereira, R.L.; Quintans-Júnior, L.J.; De Menezes, I.R.; Araújo, A.A.D.S.; De Freitas, T.S.; et al. Comparative analysis of the antibacterial and drug-modulatory effect of D-limonene alone and complexed with β-cyclodextrin. Eur. J. Pharm. Sci. 2019, 128, 158–161. [Google Scholar] [CrossRef]
- Yostawonkul, J.; Kitiyodom, S.; Kaewmalun, S.; Suktham, K.; Nittayasut, N.; Khongkow, M.; Namdee, K.; Ruktanonchai, U.R.; Rodkhum, C.; Pirarat, N.; et al. Bifunctional clove oil nanoparticles for anesthesia and anti-bacterial activity in Nile tilapia (Oreochromis niloticus). Aquaculture 2019, 503, 589–595. [Google Scholar] [CrossRef]
- Nanashima, N.; Kitajima, M.; Takamagi, S.; Fujioka, M.; Tomisawa, T. Comparison of Chemical Composition between Kuromoji (Lindera umbellata) Essential Oil and Hydrosol and Determination of the Deodorizing Effect. Molecules 2020, 25, 4195. [Google Scholar] [CrossRef]
- Luo, Y.; Peng, B.; Wei, W.; Tian, X.; Wu, Z. Antioxidant and Anti-Diabetic Activities of Polysaccharides from Guava Leaves. Molecules 2019, 24, 1343. [Google Scholar] [CrossRef]
- Yan, Y.; Li, X.; Wan, M.; Chen, J.; Li, S.; Cao, M.; Zhang, D. Effect of extraction methods on property and bioactivity of water-soluble polysaccharides from Amomum villosum. Carbohydr. Polym. 2015, 117, 632–635. [Google Scholar] [CrossRef]
- He, L.; Yan, X.; Liang, J.; Li, S.; He, H.; Xiong, Q.; Lai, X.; Hou, S.; Huang, S. Comparison of different extraction methods for polysaccharides from Dendrobium officinale stem. Carbohydr. Polym. 2018, 198, 101–108. [Google Scholar] [CrossRef]
- Vijayan, U.K.; Varakumar, S.; Singhal, R.S. A comparative account of extraction of oleoresin from Curcuma aromatica Salisb by solvent and supercritical carbon dioxide: Characterization and bioactivities. LWT 2019, 116, 108564. [Google Scholar] [CrossRef]
- Li, Y.-X.; Zhang, C.; Pan, S.; Chen, L.; Liu, M.; Yang, K.; Zeng, X.; Tian, J. Analysis of chemical components and biological activities of essential oils from black and white pepper (Piper nigrum L.) in five provinces of southern China. LWT 2020, 117, 108644. [Google Scholar] [CrossRef]
- Pejin, B.; Vujisic, L.; Sabovljevic, M.; Tesevic, V.; Vajs, V. Preliminary Data on Essential Oil Composition of the Moss Rhodobryum ontariense (Kindb.) Kindb. Cryptogam. Bryol. 2011, 32, 113–117. [Google Scholar] [CrossRef]
- Anbalagan, K.; Kumar, M.M.; Ilango, K.; Mohankumar, R.; Priya, R.L. Prelusive scale extraction of mangiferin from Mangifera indica leaves: Assessing solvent competency, process optimization, kinetic study and diffusion modelling. Ind. Crop. Prod. 2019, 140, 111703. [Google Scholar] [CrossRef]
- Sommer, A.; Mahlknecht, G.; Obermeyer, G. Measuring the Osmotic Water Permeability of the Plant Protoplast Plasma Membrane: Implication of the Nonosmotic Volume. J. Membr. Biol. 2007, 215, 111–123. [Google Scholar] [CrossRef][Green Version]
- Shang, A.; Gan, R.-Y.; Zhang, J.-R.; Xu, X.-Y.; Luo, M.; Liu, H.-Y.; Li, L.-B. Optimization and characterization of microwave-assisted hydro-distillation extraction of essential oils from Cinnamomum camphora leaf and recovery of polyphenols from extract fluid. Molecules 2020, 25, 3213. [Google Scholar] [CrossRef]
- Feng, Y.-N.; Zhang, X.-F. Polysaccharide extracted from Huperzia serrata using response surface methodology and its biological activity. Int. J. Biol. Macromol. 2020, 157, 267–275. [Google Scholar] [CrossRef]
- Hu, B.; Li, Y.; Song, J.; Li, H.; Zhou, Q.; Li, C.; Zhang, Z.; Liu, Y.; Liu, A.; Zhang, Q.; et al. Oil extraction from tiger nut (Cyperus esculentus L.) using the combination of microwave-ultrasonic assisted aqueous enzymatic method–Design, optimization and quality evaluation. J. Chromatogr. A 2020, 1627, 461380. [Google Scholar] [CrossRef]
- Jiao, Z.; Zhang, Y.; Fan, H. Ultrasonic-microwave method in preparation of polypyrrole-coated magnetic particles for vitamin D extraction in milk. J. Chromatogr. A 2016, 1457, 7–13. [Google Scholar] [CrossRef]
- Sagarika, N.; Prince, M.V.; Kothakota, A.; Pandiselvam, R.; Sreeja, R.; & Mathew, S.M. Characterization and Optimization of Microwave Assisted Process for Extraction of Nutmeg (Myristica fragrans Houtt.) Mace Essential Oil. J. Essent. Oil Bear. Plants 2018, 21, 895–904. [Google Scholar] [CrossRef]
- Zhang, H.; Cai, X.T.; Tian, Q.H.; Xiao, L.X.; Zeng, Z.; Cai, X.T.; Yan, J.Z.; Li, Q.Y. Microwave-Assisted Degradation of Polysaccharide from Polygonatum sibiricum and Antioxidant Activity. J. Food Sci. 2019, 84, 754–761. [Google Scholar] [CrossRef]
- Hashemifesharaki, R.; Xanthakis, E.; Altintas, Z.; Guo, Y.; Gharibzahedi, S.M.T. Microwave-assisted extraction of polysaccharides from the marshmallow roots: Optimization, purification, structure, and bioactivity. Carbohydr. Polym. 2020, 240, 116301. [Google Scholar] [CrossRef]
- Yu, G.; Zhu, H.; Huang, Y.; Zhang, X.; Sun, L.; Wang, Y.; Xia, X. Preparation of Daidzein microparticles through liquid antisolvent precipitation under ultrasonication. Ultrason. Sonochemistry 2021, 79, 105772. [Google Scholar] [CrossRef]
- Ekpa, O.; Fogliano, V.; Linnemann, A. Identification of the volatile profiles of 22 traditional and newly bred maize varieties and their porridges by PTR-QiTOF-MS and HS-SPME GC–MS. J. Sci. Food Agric. 2021, 101, 1618–1628. [Google Scholar] [CrossRef]
- Miladinović, D.L.; Dimitrijević, M.V.; Mihajilov-Krstev, T.M.; Marković, M.S.; Ćirić, V.M. The significance of minor components on the antibacterial activity of essential oil via chemometrics. LWT 2021, 136, 110305. [Google Scholar] [CrossRef]
- Hassanvand, F.; Nejad, A.R.; Fanourakis, D. Morphological and physiological components mediating the silicon-induced enhancement of geranium essential oil yield under saline conditions. Ind. Crop. Prod. 2019, 134, 19–25. [Google Scholar] [CrossRef]
- Chen, F.; Jia, J.; Zhang, Q.; Yang, L.; Gu, H. Isolation of essential oil from the leaves of Polygonum viscosum Buch-ham. using microwave-assisted enzyme pretreatment followed by microwave hydrodistillation concatenated with liquid–liquid extraction. Ind. Crops Prod. 2018, 112, 327–341. [Google Scholar] [CrossRef]
- Liu, Z.; Li, H.; Cui, G.; Wei, M.; Zou, Z.; Ni, H. Efficient extraction of essential oil from Cinnamomum burmannii leaves using enzymolysis pretreatment and followed by microwave-assisted method. LWT 2021, 147, 111497. [Google Scholar] [CrossRef]
- Zhang, Q.; Huo, R.; Ma, Y.; Yan, S.; Yang, L.; Chen, F. A novel microwave-assisted steam distillation approach for separation of essential oil from tree peony (Paeonia suffruticosa Andrews) petals: Optimization, kinetic, chemical composition and antioxidant activity. Ind. Crop. Prod. 2020, 154, 112669. [Google Scholar] [CrossRef]
- Du, X.; Hu, M.; Liu, G.; Qi, B.; Zhou, S.; Lu, K.; Xie, F.; Zhu, X.; Li, Y. Development and evaluation of delivery systems for quercetin: A comparative study between coarse emulsion, nano-emulsion, high internal phase emulsion, and emulsion gel. J. Food Eng. 2022, 314, 110784. [Google Scholar] [CrossRef]
- Khodaei, N.; Nguyen, M.M.; Mdimagh, A.; Bayen, S.; Karboune, S. Compositional diversity and antioxidant properties of essential oils: Predictive models. LWT 2021, 138, 110684. [Google Scholar] [CrossRef]
- Chen, Q.; Hu, Z.; Yao, F.Y.-D.; Liang, H. Study of two-stage microwave extraction of essential oil and pectin from pomelo peels. LWT 2016, 66, 538–545. [Google Scholar] [CrossRef]
- Liu, Z.; Li, H.; Zhu, Z.; Huang, D.; Qi, Y.; Ma, C.; Zou, Z.; Ni, H. Cinnamomum camphora fruit peel as a source of essential oil extracted using the solvent-free microwave-assisted method compared with conventional hydrodistillation. LWT 2022, 153, 112549. [Google Scholar] [CrossRef]
- Jassal, K.; Kaushal, S.; Rashmi; Rani, R. Antifungal potential of guava (Psidium guajava) leaves essential oil, major compounds: Beta-caryophyllene and caryophyllene oxide. Arch. Phytopathol. Plant Prot. 2021, 54, 2034–2050. [Google Scholar] [CrossRef]








| Run | BBD Experiments | ANOVA | |||||||||||
|---|---|---|---|---|---|---|---|---|---|---|---|---|---|
| X1 | X2 (w) | X3 (min) | YEO (mL/kg·DW) | Source of Variation | Sum of Squares | Degree of Freedom | Mean Square | F-Value | p-Value | ||||
| 1 | 8 | 700 | 45 | 9.61 | Model | 24.21 | 9 | 2.69 | 88.32 | <0.0001 ** | |||
| 2 | 10 | 700 | 40 | 9.89 | X1 | 13.91 | 1 | 13.91 | 456.79 | <0.0001 ** | |||
| 3 | 6 | 700 | 40 | 6.33 | X2 | 4.98 | 1 | 4.98 | 163.41 | <0.0001 ** | |||
| 4 | 8 | 385 | 45 | 7.45 | X3 | 1.22 | 1 | 1.22 | 39.95 | 0.0004 ** | |||
| 5 | 8 | 540 | 40 | 7.95 | X12 | 0.55 | 1 | 0.55 | 18.19 | 0.0037 ** | |||
| 6 | 6 | 385 | 40 | 5.95 | X22 | 0.35 | 1 | 0.35 | 11.45 | 0.0117 * | |||
| 7 | 8 | 540 | 40 | 8.11 | X32 | 0.3 | 1 | 0.3 | 9.69 | 0.0170 * | |||
| 8 | 8 | 540 | 40 | 7.98 | X1X2 | 0.93 | 1 | 0.93 | 30.57 | 0.0009 ** | |||
| 9 | 10 | 385 | 40 | 7.58 | X1X3 | 1.88 | 1 | 1.88 | 61.62 | 0.0001 ** | |||
| 10 | 6 | 540 | 45 | 6.28 | X2X3 | 0.12 | 1 | 0.12 | 4.02 | 0.0849 | |||
| 11 | 8 | 700 | 35 | 8.33 | Residual | 0.21 | 7 | 0.03 | |||||
| 12 | 10 | 540 | 45 | 10.33 | Lack of fit | 0.16 | 3 | 0.05 | 3.7 | 0.1193 | |||
| 13 | 8 | 385 | 35 | 6.87 | Pure error | 0.05 | 4 | 0.0105 | |||||
| 14 | 6 | 540 | 35 | 7.02 | Corrected total | 24.42 | 16 | ||||||
| 15 | 10 | 540 | 35 | 8.33 | Credibility analysis of the regression equations | ||||||||
| 16 | 8 | 540 | 40 | 8.21 | Index mark | Standard deviation | Mean | CV% | Press | R2 | Adjust R2 | Predicted R2 | Adequacy precision |
| 17 | 8 | 540 | 40 | 8.19 | Y | 0.17 | 7.91 | 2.21 | 2.6 | 0.9913 | 0.98 | 0.8937 | 34.151 |
| Run | BBD Experiments | ANOVA | |||||||||||
|---|---|---|---|---|---|---|---|---|---|---|---|---|---|
| X1 | X2 (w) | X3 (min) | Ypolysaccharides (g/kg·DW) | Source of Variation | Sum of Squares | Degree of Freedom | Mean Square | F-Value | p-Value | ||||
| 1 | 8 | 700 | 45 | 46.23 | Model | 1397.94 | 9 | 155.33 | 86.13 | <0.0001 | |||
| 2 | 10 | 700 | 40 | 48.9 | X1 | 812.45 | 1 | 812.45 | 450.50 | <0.0001 | |||
| 3 | 6 | 700 | 40 | 22.96 | X2 | 84.05 | 1 | 84.05 | 46.60 | 0.0002 | |||
| 4 | 8 | 385 | 45 | 36.29 | X3 | 71.70 | 1 | 71.70 | 39.76 | 0.0004 | |||
| 5 | 8 | 540 | 40 | 43.49 | X12 | 25.35 | 1 | 25.35 | 14.06 | 0.0072 | |||
| 6 | 6 | 385 | 40 | 21.85 | X22 | 5.64 | 1 | 5.64 | 3.13 | 0.1203 | |||
| 7 | 8 | 540 | 40 | 44.56 | X32 | 9.73 | 1 | 9.73 | 5.40 | 0.0531 | |||
| 8 | 8 | 540 | 40 | 44.51 | X1X2 | 271.77 | 1 | 271.77 | 150.69 | <0.0001 | |||
| 9 | 10 | 385 | 40 | 37.72 | X1X3 | 31.99 | 1 | 31.99 | 17.74 | 0.0040 | |||
| 10 | 6 | 540 | 45 | 23.15 | X2X3 | 54.46 | 1 | 54.46 | 30.20 | 0.0009 | |||
| 11 | 8 | 700 | 35 | 35.18 | Residual | 12.62 | 7 | 1.80 | |||||
| 12 | 10 | 540 | 45 | 44.93 | Lack of fit | 8.90 | 3 | 2.97 | 3.19 | 0.1462 | |||
| 13 | 8 | 385 | 35 | 31.48 | Pure error | 3.72 | 4 | 0.93 | |||||
| 14 | 6 | 540 | 35 | 21.48 | Corrected total | 1410.56 | 16 | ||||||
| 15 | 10 | 540 | 35 | 38.51 | Credibility analysis of the regression equations | ||||||||
| 16 | 8 | 540 | 40 | 42.2 | Index mark | Standard deviation | Mean | CV% | Press | R2 | Adjust R2 | Predicted R2 | Adequacy precision |
| 17 | 8 | 540 | 40 | 43.48 | Y | 1.34 | 36.88 | 3.64 | 148.21 | 0.9911 | 0.9795 | 0.8949 | 27.729 |
| No. A | Components | Molecular Formula | RI B | CAS Number | RA (%) C | ||
|---|---|---|---|---|---|---|---|
| EO a | EO b | EO c | |||||
| 1 | Benzaldehyde | C11H14O | 1022 | 000100-52-7 | 0.09 | 0.30 | 0.14 |
| 2 | D-limonene | C10H16 | 1079 | 005989-27-5 | 0.32 | 8.06 | 0.45 |
| 3 | Alpha-terpineol | C10H18O | 1241 | 000098-55-5 | 0.11 | 0.17 | 0.10 |
| 4 | Cyclohexasiloxane,2,2,4,4,6,6,8,8,10,10,12,12-dodecamethyl- | C12H36O6Si6 | 1343 | 000540-97-6 | 0.16 | - | 0.40 |
| 5 | A-cubebene | C15H24 | 1362 | 017699-14-8 | 0.42 | 0.38 | 0.07 |
| 6 | Eugenol | C10H12O2 | 1367 | 000097-53-0 | 1.19 | - | - |
| 7 | (+)-Cyclosativene | C15H24 | 1374 | 022469-52-9 | - | - | 0.14 |
| 8 | Tricyclo (4).4.0.02,7]dec-3-ene,1,3-dimethyl-8-(1-methylethyl)-, (1R,2S,6S,7S,8S) | C15H24 | 1381 | 003856-25-5 | 9.66 | - | - |
| 9 | Tricyclo (6.3.0.0(2,4) undec | C20H34O2Si | 1396 | 1000152-25-6 | - | - | 0.06 |
| 10 | A-gurjunene | C15H22 | 1402 | 000489-40-7 | 1.43 | 1.50 | 1.97 |
| 11 | l-caryophyllene | C15H24 | 1410 | 000087-44-5 | 28.36 | 24.06 | 24.46 |
| 12 | 1,6-Cyclodecadiene,1-methyl-5-methylene-8-(1-methylethyl)-, (1E,6E,8S)- | C15H24 | 1416 | 023986-74-5 | 0.22 | - | - |
| 13 | 1H-Cyclopropa[a]naphthalene,1a,2,3,5,6,7,7a,7b-octahydro-1,1,7,7a-tetramethyl- | C15H24 | 1419 | 017334-55-3 | 0.10 | 0.27 | 0.12 |
| 14 | Aromandendrene | C15H24 | 1424 | 000489-39-4 | 5.18 | 4.68 | 0.76 |
| 15 | Cis-muurola-3,5-diene | C15H24 | 1431 | 1000365-95-4 | 0.22 | 0.23 | 0.15 |
| 16 | Humulene | C15H24 | 1434 | 006753-98-6 | 3.91 | - | 3.44 |
| 17 | Alloaromadendrene | C15H24 | 1439 | 025246-27-9 | 1.97 | 1.75 | 1.80 |
| 18 | (+)-epi-bicyclosesquiphellandrene | C6H10O6 | 1447 | 054274-73-6 | 0.99 | - | - |
| 19 | Gamma-muurolene | C15H24 | 1449 | 030021-74-0 | 1.17 | - | 1.20 |
| 20 | Naphthalene,1,2,3,4,4a,5,6,8a-octahydro-4a, | C15H24 | 1458 | 000473-13-2 | - | 0.78 | - |
| 21 | Azulene,1,2,3,3a,4,5,6,7-octahydro-1,4-dimethyl-7 | C15H24 | 1463 | 022567-17-5 | 2.11 | - | - |
| 22 | Cis-alpha-bisabolene | C15H24O | 1466 | 029837-07-8 | 1.83 | 1.41 | - |
| 23 | Beta.-bisabolene | C15H24 | 1471 | 000495-61-4 | 0.96 | 0.78 | 0.96 |
| 24 | (-)-g-cadinene | C15H24 | 1476 | 039029-41-9 | 0.97 | 1.07 | - |
| 25 | l-calamenene | C18H20 | 1483 | 000483-77-2 | 11.47 | 8.87 | 10.82 |
| 26 | Naphthalene,1,2,3,4,4a,7-hexahydro-1,6-dimethyl-4-(1-methylethyl)- | C12H16 | 1489 | 016728-99-7 | 2.81 | 2.49 | 2.66 |
| 27 | Alpha-calacorene | C15H20 | 1497 | 021391-99-1 | 0.27 | - | - |
| 28 | Epiglobulol | C26H28O7 | 1514 | 1000150-05-1 | 1.29 | 1.19 | - |
| 29 | 1H-Cycloprop[e]azulen-4-ol, decahydro-1,1,4,7-tetramethyl- | C15H26O | 1518 | 000552-02-3 | - | - | 0.65 |
| 30 | Globulol | C15H26O | 1532 | 000489-41-8 | 11.31 | 9.04 | 10.69 |
| 31 | Ledol | C15H26O | 1544 | 000577-27-5 | 4.10 | 3.78 | 4.48 |
| 32 | Naphthalene,1,2,3,4,4a,7-hexahydro-1,6-dimethyl-4-(1-methylethyl)- | C15H24 | 1560 | 016728-99-7 | 2.33 | 2.57 | - |
| 33 | Tau-cadinol | C15H26O | 1571 | 005937-11-1 | 2.59 | 7.97 | 6.96 |
| 34 | Copaene | C15H24 | 1573 | 003856-25-5 | - | 1.09 | - |
| 35 | Naphthalene,1,2,3,5,6,7,8,8a-octahydro-1-methyl-6-methylene-4-(1-methylethyl)- | C15H24 | 1580 | 150320-52-8 | 0.02 | - | - |
| 36 | Alpha-cadinol | C15H26O | 1581 | 000481-34-5 | 0.02 | - | 3.39 |
| 37 | 2,6,10-Dodecatrien-1-ol,3,7,11-trimethyl-, 1-acetate, (2E,6E)- | C17H28O2 | 1630 | 004128-17-0 | - | 0.03 | - |
| 38 | Eucalyptol | C10H18O | 1682 | 000470-82-6 | - | - | 0.08 |
| 39 | Phenol,4-(1,1-dimethylethyl)-2-methyl- | C11H16O | 1738 | 000098-27-1 | - | - | 0.03 |
| 40 | 3,7-dimethyl-, acetate, (z)-6-octadien-1-ol | C12H20O2 | 1770 | 000141-12-8 | - | - | 0.06 |
| 41 | Alpha-Copaene | C15H24 | 1781 | 1000360-33-0 | - | - | 8.71 |
| 42 | 1H-cyclopenta (1,3)cyclopropa (1,2 | C15H24 | 1816 | 013744-15-5 | - | - | 0.24 |
| 43 | Selina-3,7(11)-diene | C15H24 | 1821 | 006813-21-4 | - | - | 0.07 |
| 44 | Naphthalene, decahydro-4a-methyl | C15H24 | 1858 | 017066-67-0 | 0.73 | - | 0.10 |
| 45 | Naphthalene,1,2,4a,5,6,8a-hexahydro-4, | C15H24 | 1877 | 000483-75-0 | 0.92 | - | - |
| 46 | Tricyclo (5.4.0.02),8undec-9-ene,2,6,6,9-tetramethyl-, (1R,2S,7R,8R) | C15H24 | 1894 | 005989-08-2 | - | - | 0.18 |
| 47 | 1,1,5-Trimethyl-1,2-dihydrona | C21H24N2O | 1897 | 1000357-25-8 | - | - | 0.28 |
| 48 | Epiglobulol | C26H28O | 1914 | 1000150-05-1 | 1.28 | - | - |
| 49 | 6,10-dodecatrien-1-ol, 3,7,11-trimethyl-2 | C15H26O | 2031 | 004602-84-0 | 0.65 | 0.66 | - |
| 50 | Heptaldehyde | C7H14O | 2176 | 000111-71-7 | 0.01 | 0.01 | - |
| 51 | 6,6-trimethyl-(1 theta)-bicyclo [3.1.1]hept-2-en | C10H16 | 2201 | 007785-70-8 | - | 0.05 | - |
| 52 | 1-octen-3-ol | C8H16O | 2234 | 003391-86-4 | 0.01 | 0.01 | - |
| 53 | Beta-pinene | C10H16 | 2235 | 000127-91-3 | - | 0.01 | - |
| 54 | 3-Cyclohexadiene, 2-methyl-5-(1-methylethyl)-1 | C10H16 | 2257 | 000099-83-2 | - | 0.02 | - |
| 55 | 1,3-Cyclohexadiene,1-methyl-4-(1-methylethyl)- | C10H16 | 2268 | 000099-86-5 | 0.01 | 0.01 | 0.01 |
| 56 | P-isopropyltoluene | C10H14 | 2375 | 000099-87-6 | 0.02 | 0.01 | 0.03 |
| 57 | Trans-beta-ocimene | C10H16 | 2486 | 003779-61-1 | 0.17 | 0.11 | - |
| 58 | Beta-ocimene | C10H16 | 2596 | 013877-91-3 | 0.02 | 0.01 | - |
| 59 | G-terpinene | C10H16 | 2626 | 000099-85-4 | - | - | 0.03 |
| 60 | Terpinolene | C10H16 | 2749 | 000586-62-9 | - | - | 0.03 |
| 61 | Linalool | C10H18O | 2857 | 000078-70-6 | - | 0.02 | - |
| 62 | 3,4-dimethyl-2,4,6-octatriene | C10H16 | 2881 | 057396-75-5 | - | - | 0.03 |
| 63 | 3-cyclohexen-1-ol,4-methyl-1-(1-methylethyl)-, (1R)- | C10H18O | 2931 | 020126-76-5 | - | - | 0.02 |
| 64 | 4-acetylbenzoic acid | C9H8O3 | 2938 | 000586-89-0 | 0.04 | 0.01 | - |
| 65 | 2,6-octadien-1-ol, 2,7-dimethyl- | C10H18O | 2968 | 022410-74-8 | 0.01 | 0.01 | - |
| 66 | Pyrazine, trimethyl(2-methylpropyl)- (9CI) | C11H18N2 | 3008 | 046187-37-5 | 0.02 | 0.01 | - |
| 67 | 2,2-dimethyl-3-methylene-, (1R)-bicyclo (2.2.1)heptane | C10H16 | 3052 | 005794-03-6 | - | - | 0.01 |
| 68 | Cis-beta-guaiene | C15H24 | 3065 | 087745-31-1 | - | - | 0.02 |
| 69 | (+)-cyclosativene | C15H24 | 3075 | 022469-52-9 | 0.14 | 0.07 | - |
| 70 | Isoledene | C15H24 | 3079 | 1000156-10-8 | 0.07 | 0.01 | - |
| 71 | Alpha-bourbonene | C15H24 | 3088 | 1000293-01-9 | - | 0.01 | - |
| 72 | 1,4,7,-cycloundecatriene, 1,5,9,... | C15H24 | 3134 | 1000062-61-9 | 3.48 | 2.42 | - |
| 73 | Ylangene | C15H24 | 3194 | 014912-44-8 | 0.14 | 0.02 | - |
| 74 | Bicyclo undec-4-ene,4,11,11-trimethyl-8-methylene-, (1R,4Z,9S)- | C15H24 | 3207 | 000118-65-0 | 0.06 | - | |
| 75 | G-selinene | C15H24 | 3218 | 000515-17-3 | 0.61 | 0.41 | - |
| 76 | 2,6,10,14-hexadecatetraen-1-ol, 3,7,11,15-tetramethyl | C20H34O | 3346 | 007614-21-3 | - | 0.01 | |
| A | B (mm) | Samples | ||
|---|---|---|---|---|
| Positive | EO Samples | Blank | ||
| SA | 23.7 ± 1.1 a | ![]() | ![]() | ![]() |
| RS | 21.1 ± 0.9 a | ![]() | ![]() | ![]() |
| ECCB | 20.1 ± 0.5 a | ![]() | ![]() | ![]() |
| SA | RS | ECCB | |
|---|---|---|---|
| Pearson correlation | 0.863 * | 0.817 * | 0.841 * |
| Significance (bilateral) | 0.027 | 0.047 | 0.036 |
Publisher’s Note: MDPI stays neutral with regard to jurisdictional claims in published maps and institutional affiliations. |
© 2022 by the authors. Licensee MDPI, Basel, Switzerland. This article is an open access article distributed under the terms and conditions of the Creative Commons Attribution (CC BY) license (https://creativecommons.org/licenses/by/4.0/).
Share and Cite
Zhang, X.; Huang, Y.; Zhang, L.; Zhu, H.; Niu, Y.; An, Y.; Liu, Z. An Efficient Approach for Separating Essential Oil and Polysaccharides Simultaneously from Fresh Leaves of Guajava by Microwave-Mediated Hydrodistillation with Lithium Salts and Antibacterial Activity of Essential Oil. Separations 2022, 9, 162. https://doi.org/10.3390/separations9070162
Zhang X, Huang Y, Zhang L, Zhu H, Niu Y, An Y, Liu Z. An Efficient Approach for Separating Essential Oil and Polysaccharides Simultaneously from Fresh Leaves of Guajava by Microwave-Mediated Hydrodistillation with Lithium Salts and Antibacterial Activity of Essential Oil. Separations. 2022; 9(7):162. https://doi.org/10.3390/separations9070162
Chicago/Turabian StyleZhang, Xiaonan, Yan Huang, Lubin Zhang, Hongwei Zhu, Yaqian Niu, Yimin An, and Zhiwei Liu. 2022. "An Efficient Approach for Separating Essential Oil and Polysaccharides Simultaneously from Fresh Leaves of Guajava by Microwave-Mediated Hydrodistillation with Lithium Salts and Antibacterial Activity of Essential Oil" Separations 9, no. 7: 162. https://doi.org/10.3390/separations9070162
APA StyleZhang, X., Huang, Y., Zhang, L., Zhu, H., Niu, Y., An, Y., & Liu, Z. (2022). An Efficient Approach for Separating Essential Oil and Polysaccharides Simultaneously from Fresh Leaves of Guajava by Microwave-Mediated Hydrodistillation with Lithium Salts and Antibacterial Activity of Essential Oil. Separations, 9(7), 162. https://doi.org/10.3390/separations9070162